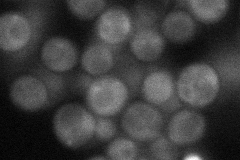
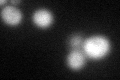
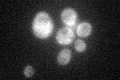

View description
Ski complex component and TPR protein, mediates 3'-5' RNA degradation by the cytoplasmic exosome; null mutants have superkiller phenotype of increased viral dsRNAs and are synthetic lethal with mutations in 5'-3' mRNA decay
Localization:
Intensity:
Fold change:
Significance:
-
C’ GFP library in SD

cytosol51.96 -
N' NOP1pr-GFP in SD

cytosol99.6696 -
N' TEF2pr-mCherry in SD

cytosol20.2214 -
N' NATIVEpr-GFP in SD
cytosol37.7992 -
N' TEF2pr-VC and Cyto-VN in SD

below threshold27.0415 -
C’ GFP library in SD+DTT
cytosol50.330.96No -
C’ GFP library in SD+H2O2

cytosol62.561.2No -
C’ GFP library in Starvation Media
cytosol49.790.95No -
C’ GFP library on the background of Pup2-DaMP

cytosol -
C’ GFP library on the background of CCT mutant

cytosol51.18690.985005No
